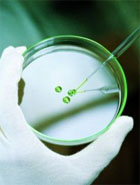

Doktor Elżbieta Suchowilska z Katedry Hodowli Roślin i Nasiennictwa Wydziału Kształtowania Środowiska i Rolnictwa UWM została stypendystką Ministra Nauki i Szkolnictwa Wyższego. Stypendium przyznawane wybitnym młodym naukowcom otrzymała za badania nad starymi oplewionymi gatunkami pszenic - orkiszem, płaskurką i samopszą.

Władze Uniwersytetu Warmińsko-Mazurskiego podpisały porozumienie z Polskim Radiem Olsztyn. Z podpisanej umowy mogą się cieszyć przede wszystkim studenci dziennikarstwa i komunikacji społecznej.

W nadchodzącym roku akademickim Uniwersytet Warmińsko-Mazurski zbliży się do sfinalizowania jednego z dwóch sztandarowych inwestycji realizowanych na uczelni - Projektu BIO.

Wydział Bioinżynierii Zwierząt świętuje. 60 lat temu pierwsi studenci ówczesnego Wydziału Zootechnicznego odebrali swoje indeksy podczas inauguracji roku akademickiego Wyższej Szkoły Rolniczej w Olsztynie. To był początek.
160 imprez będzie czekało na uczestników 8. Olsztyńskich Dni Nauki i Sztuki, które odbędą się w dniach 22-25 września. Koordynatorem wydarzenia jest Biuro Nauki i Współpracy z Gospodarką, Uniwersytetu Warmińsko-Mazurskiego w Olsztynie.

Rozpoczął się nabór uzupełniający na studia stacjonarne i niestacjonarne. To dla niektórych ostatni dzwonek, żeby dostać się na studia i nie zmarnować roku.

Najlepsi studenci wybierający kierunek ochrona środowiska na Wydziale Kształtowania Środowiska i Rolnictwa UWM dostaną miesięczne stypendium w wysokości ok. 1 tys. zł. Dodatkowo, niezależnie od innych stypendiów.

Szpital Uniwersytecki ma nowego dyrektora. Tadeusza Myśliwca zastąpił na tym stanowisku Leszek Dudziński. Nowy dyrektor, decyzją rektora prof. Józefa Górniewicza, obejmie swoje obowiązki od pierwszego września.

Rekonstrukcje dwóch historycznych osad powstaną na terenie Skansenu Archeologicznego w Biskupinie (woj. kujawsko-pomorskie). Przedsięwzięcie będzie możliwe dzięki dotacji z funduszy UE.

Jak się ubierać na spotkania biznesowe albo jak zachować się podczas przyjęć - takich kwestii związanych z etykietą będą się uczyć od października studenci Uniwersytetu Warmińsko-Mazurskiego w Olsztynie. Obowiązkowe kursy obejmą w tym roku 9 tysięcy studentów.

Przy 3-stopniowym w skali Beauforta wietrze i słonecznej pogodzie dwunastoosobowa załoga Akademickiego Klubu Żeglarskiego „Szkwał" UWM jako pierwsza dopłynęła do mety IX Międzynarodowych Długodystansowych Mistrzostw Polski w klasie DZ. Mistrzostwa zostały rozegrane 14 sierpnia w Giżycku na jeziorze Kisajno.

Urząd Marszałkowski zapłaci 26 mln złotych Uniwersytetowi Warmińsko-Mazurskiemu w Olsztynie za sprzedaż budynku przy ul. Głowackiego 17. Od września budynek zaczną przejmować urzędnicy. Przeprowadzka studentów i pracowników Wydziału Nauk Społecznych odbędzie się w trzech etapach.

Kolejny sezon siatkarskiej PlusLigi startuje pod koniec października. Tymczasem zespół AZS UWM Olsztyn rozpoczyna przygotowania do rozgrywek. Zawodnicy spotkali się na pierwszym wspólnym treningu.

"Kotarbiński" uruchomił II termin rekrutacji na studia. Obejmuje on studia stacjonarne i niestacjonarne na kierunkach: zarządzanie, ekonomia, europeistyka, pedagogika, kulturoznawstwo oraz informatykę i mechatronikę na studiach inżynierskich.

Chcesz otrzymać od nas ratę w prezencie? Jeśli tak, zapisz się na jeden z dwuletnich kierunków z oferty szkół policealnych TEB Edukacja i skorzystaj z aktualnej promocji 1 RATA GRATIS!

Kolejna uczelnia postanowiła promować się w modny ostatnio sposób - teledyskiem z udziałem studentów. W Olsztyńskiej Szkole Wyższej powstał lip-dub.

Nowy projekt w Olsztyńskiej Wyższej Szkole Informatyki i Zarządzania! Stworzenie Wirtualnego Środowiska Edukacyjnego – strony internetowej, która będzie źródłem materiałów edukacyjnych i szkoleniowych dla nauczycieli w szkolnictwie zawodowym – to założony efekt projektu zatytułowanego „Technologie informacyjne w nauczaniu przedmiotów ścisłych związanych z elektroniką, automatyką, mechatroniką oraz budownictwem”.

Uniwersytet Warmińsko-Mazurski w Olsztynie prowadzi dodatkowy (wrześniowy) nabór kandydatów na I rok studiów stacjonarnych i niestacjonarnych w roku akademickim 2010/2011. Zachęcamy do zapoznania się z listą kierunków,na które można się jeszcze rekrutować.

W sobotę 10 lipca odbyła się uroczystość wręczenia świadectw ukończenia studiów podyplomowych 5 grup studentów Wydziału Nauk Ekonomicznych - Zarządzanie Funduszami Unijnymi i Menedżerskie.

Masz ciekawy pomysł na film krótkometrażowy? Zgłoś się do konkursu organizowanego przez Katedrę Socjologii UWM podczas VIII edycji Olsztyńskich Dni Nauki.